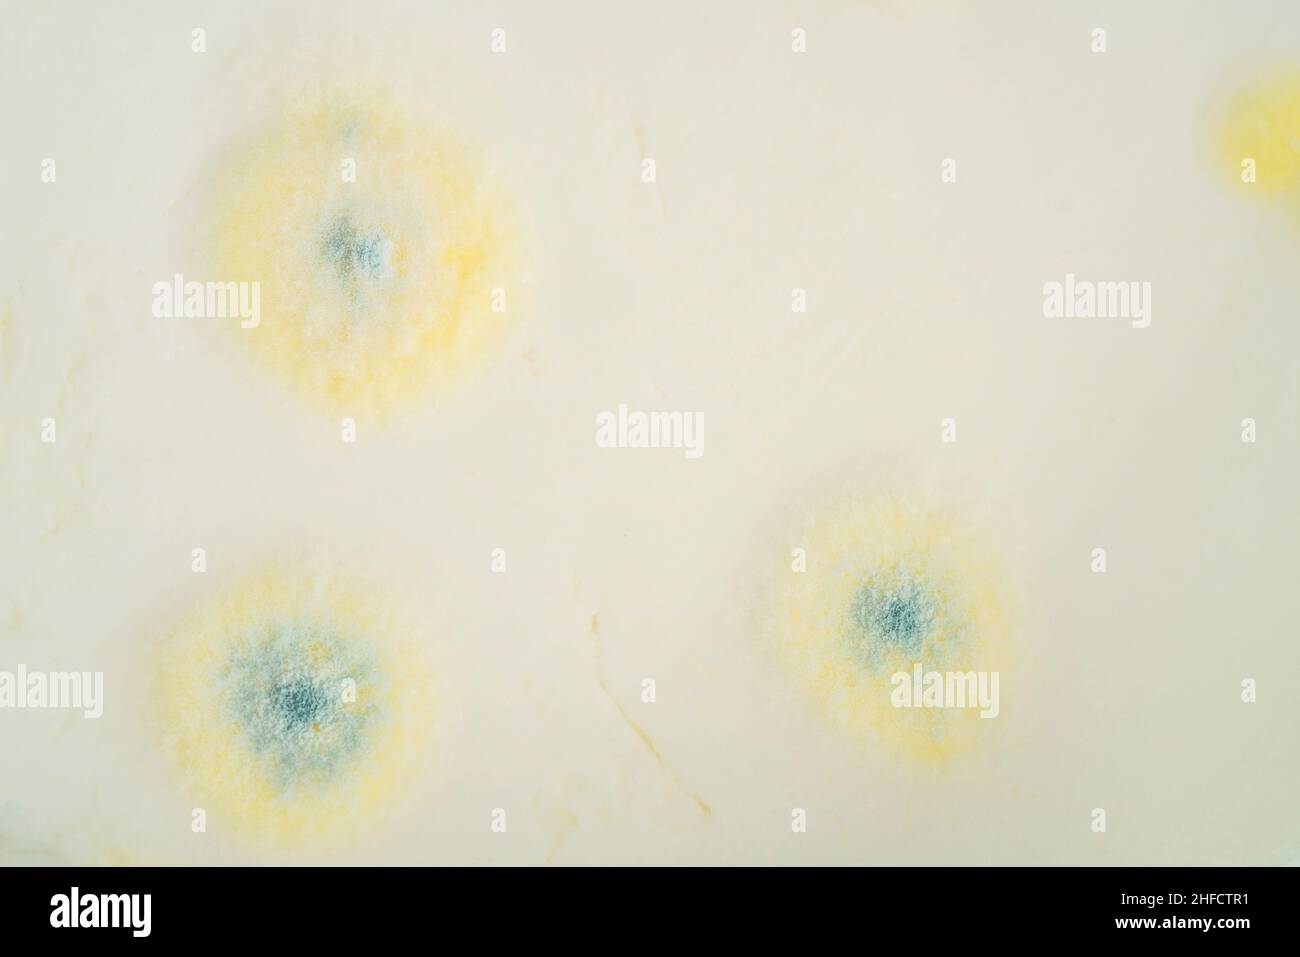
cibo ammuffito, la crescita di muffa sullo yogurt o sulla superficie dei prodotti lattiero-caseari ha superato la data di scadenza. marcio di fondo yogurt o yogurt Foto Stock

cibo ammuffito, la crescita di muffa sullo yogurt o sulla superficie dei prodotti lattiero-caseari ha superato la data di scadenza. marcio di fondo yogurt o yogurt
RFID:ID dell’immagine:2HFCTR1
Detagli dell'immagine
Collaboratore:
brn rikurID dell’immagine:
2HFCTR1Dimensioni dei file:
120,7 MB (1,7 MB Download compresso)Liberatorie:
Modello - no | Proprietà - noMi occorre una liberatoria?Dimensioni:
7952 x 5304 px | 67,3 x 44,9 cm | 26,5 x 17,7 inches | 300dpiData acquisizione:
12 novembre 2021